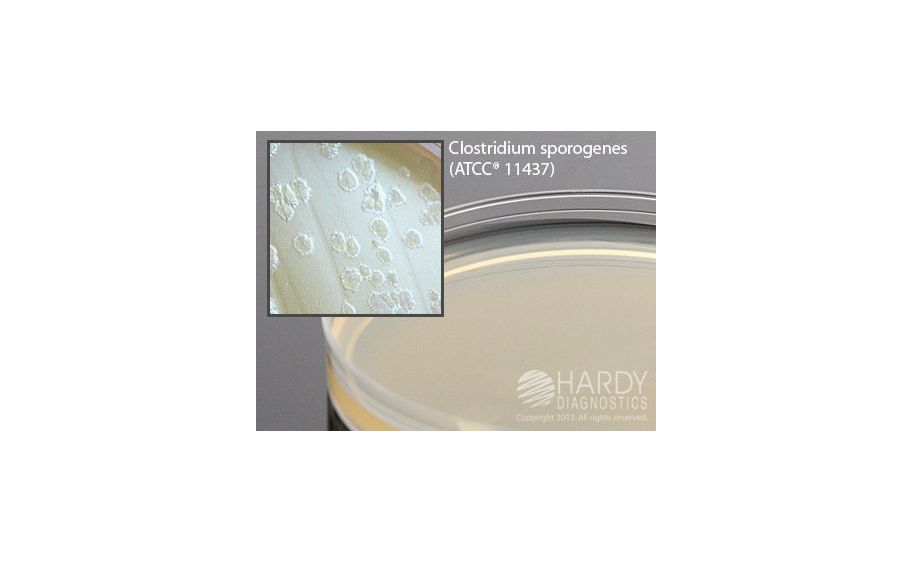
main product photo

Need Help?
800-229-7252

AGAR EGG YOLK MODIF 15X100 MM 18 ML FILL
1
/
PK
Lead Time
12 Day(s)
SKU
VWR75813-978-PK
MFRPN
G215
AGAR EGG YOLK MODIF 15X100 MM 18 ML FILL
Egg Yolk Agar, Modified, for Clostridium, 18ml fill, 15x100mm plate Egg Yolk Agar, Modified, for Clostridium, 18ml fill, 15x100mm plate, For the isolation, cultivation, and differentiation of Clostridium spp. and other anaerobic bacteria.
| Manufacturer | Hardy Diagnostics |
|---|---|
| MFRPN | G215 |
| Lead Time | 12 Day(s) |
| UNSPSC Code | 12000000 |
Write Your Own Review